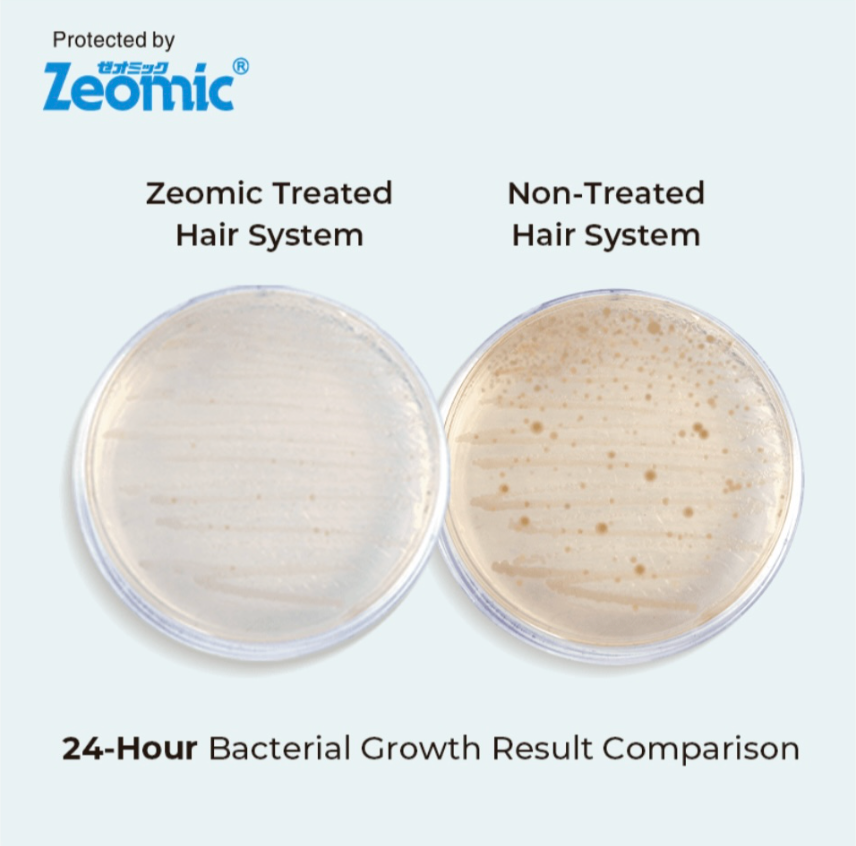
For Bald Men's Wavy Glueless 360 Full Swiss Lace Wig, Anti-Slip PU Cap Real Scalp Effect 8x10, 6 Inches (Best for Active Lifestyle)

Turn heads and express your unique style with Noble Hair New York’s premium fashion wigs—designed for bold beauty and everyday glamour. Made with high-quality human hair, these wigs offer vibrant color, volume, and versatile styling options that let you switch up your look in minutes. Whether you’re going for sleek and chic, big and bold, or soft and romantic, our fashion wigs give you the freedom to transform your hair without commitment or damage. Comfortable, breathable caps ensure a secure fit, so you can wear your confidence all day long and elevate your look effortlessly!
-
Experience natural beauty and all-day comfort with our premium hairpiece, designed to blend effortlessly while offering a flawless, realistic look. Made from Indian remy human hair and
-
Crafted with ultra-soft Swiss lace which is virtually invisible transparent lace, this piece delivers a scalp-like appearance that matches a wide range of skin tones. Whether you’re looking to add fullness, conceal thinning areas, or elevate your protective style, this lightweight and breathable solution is the perfect choice.
-
Made with anti-itch, breathable materials, it keeps your scalp cool and irritation-free — even with extended wear.